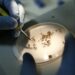
Brasil contabiliza cerca de 1.600 mortes por dengue em 2024; número é o mais alto desde o ano 2000

Mesmo com a presença de sol em muitas das capitais, a temperatura deve cair neste fim de semana em algumas das regiões brasileiras. O fator se deve a primeira massa de ar frio polar continental do outono de 2024, que chega agora, com mais força, nos estados do Sul, do Sudeste e em Mato Grosso do Sul.
Desde quarta-feira (17), a massa de ar frio vem se deslocando sobre o interior do Sul do Brasil, o que causou um resfriamento mais intenso. Nesta sexta-feira (19), o país chegou a registrar sua primeira temperatura abaixo de 0°C. A cidade “premiada” foi São Joaquim, em Santa Catarina, onde os termômetros marcaram -0,1°C.
Para este sábado (20), há a possibilidade de novos recordes de menor temperatura do ano, segundo a Climatempo.
Veja quais capitais podem bater recorde:
São Paulo
- Temperatura mínima prevista de 14°C (segundo dia consecutivo).
- A máxima deve chegar a 26°C e não deve chover. A previsão do tempo é de que haja sol com a presença de algumas nuvens.
Rio de Janeiro
- Temperatura mínima prevista de 16°C.
- Máxima pode chegar a 28°C. Também fará sol e não há previsão de chuvas.
Vitória
- Temperatura mínima prevista de 20°C (segundo dia consecutivo)
- Máxima de 28°C. Dia deve ser de sol com algumas nuvens e névoa ao amanhecer. Noite com poucas nuvens.
Belo Horizonte
- Temperatura mínima prevista de 15°C
- Máxima prevista é de 28°C. O sol também deve aparecer e não há previsão de chuvas.
Veja as previsões para outras capitais neste fim de semana:
Em Curitiba, Sul do país, o sol aparece e não deve ter chuvas. A mínima é de 9ºC e a máxima é de 23°C. Para Florianópolis, Santa Catarina, a previsão é de sol. A mínima é de 16ºC. Já a máxima é de 25°C.
Em Salvador, na Bahia, a mínima é de 25ºC e a máxima de 29°C. Apesar da presença do sol ao longo do dia, o tempo deve ser nublado com possibilidade de chuva a qualquer hora. Em Natal, Rio Grande do Norte, o tempo aparece nublado e também com possibilidade de chuva ao longo do dia. A mínima é de 24ºC e máxima prevista é de 30°C.
Em Belém, Pará, deve fazer sol com chuvas rápidas durante o dia e à noite. A mínima é de 24ºC e a máxima deve ser de 33°C. Já em Palmas, Tocantins, a mínima é de 19ºC. As temperaturas devem chegar a 31°C. A previsão é de sol e com aumento de nuvens pela manhã.
Em Goiânia, o sol também aparece juntamente com nuvens pela manhã. Pancadas de chuva durante a tarde também estão previstas. À noite, o tempo fica aberto. A mínima é de 22ºC. A máxima deve ser de 31°C
Alerta de chuvas:
O Instituto Nacional de Meteorologia (Inmet), emitiu alertas de chuvas intensas para grande parte das regiões Norte, Nordeste e Centro-Oeste do país neste final de semana.
As chuvas podem chegar a 50 milímetros por dia, com ventos de até 60 km/h. Na maior parte dos estados, há baixo risco de corte de energia elétrica, queda de galhos de árvores, alagamentos e de descargas elétricas.
A região de maior atenção é no extremo norte da região Nordeste, onde pode chover 100 milímetros por dia e os ventos podem chegar a 100 km/h.

Comentários sobre este post